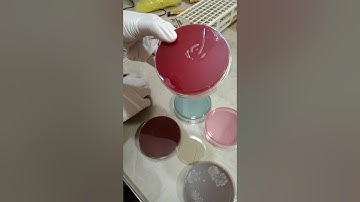
Identification of Culture Media

⬇ DOWNLOAD NOW
Jika muncul iklan pop-up, tutup lalu klik tombol kembali
Download lagu PRACTICAL FILE OF ZOOLOGY (MICROBIOLOGY) PART 1 B.Sc. 3rd YEAR secara gratis hanya untuk keperluan promosi. Dukung artis favorit kamu dengan membeli musik original di iTunes atau platform resmi lainnya.
Identification of Culture Media
Identification of Culture Media PART-1 ZOOLOGY 1st PAPER BSc 3rd year 5th semester PRACTICAL FILE.
PART-1 ZOOLOGY 1st PAPER BSc 3rd year 5th semester PRACTICAL FILE. ponds water under the microscope slide show of stracture Algae# volvox
ponds water under the microscope slide show of stracture Algae# volvox #anatomy #kidney #shortvideo #educationalvideo #biology
#anatomy #kidney #shortvideo #educationalvideo #biology PRACTICAL FILE OF ZOOLOGY B.Sc. 3rd YEAR #bsc #practicalfile #bsc3rdyearzoology #zoology
PRACTICAL FILE OF ZOOLOGY B.Sc. 3rd YEAR #bsc #practicalfile #bsc3rdyearzoology #zoology B.Sc. 3rd Year Zoology Practical File in Hindi Download PDF | Final Year Zoology Practical #mp #yt
B.Sc. 3rd Year Zoology Practical File in Hindi Download PDF | Final Year Zoology Practical #mp #yt Zoology Practical in Lab
Zoology Practical in Lab 1st year zoology practical ।। experiment no 1 ।। Amoeba ।। @let's run to learn
1st year zoology practical ।। experiment no 1 ।। Amoeba ।। @let's run to learn